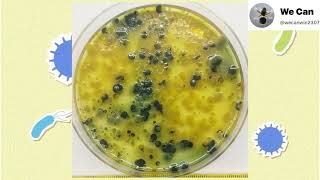

Welcome to the ‘We Can’ YouTube channel! I’m Saravanan Arumugam, a Ph.D. research scholar and an expert in aquatic animal health and statistical analysis. This channel is a fountain of knowledge for everything related to aquaculture and shrimp farming. We aim to provide invaluable insights for farmers, students, and researchers. Our commitment is to sustainable shrimp farming practices, encompassing everything from hatchery operations to advanced farming techniques, production processes, and effective disease management. We also offer deep dives into laboratory methods, cutting-edge Research & Development, and statistical analysis to propel your career in aquaculture. I can communicate with Tamil, Malayalam, Telugu, and English, I bring a diverse linguistic approach to our content. Subscribe to ‘We Can’ and enhance your proficiency in sustainable shrimp farming!
Water Filtration Importance in Shrimp Farming | 20–120 Mesh Filter System | நீர் வடிகட்டல் ரகசியம் 🦐
Shared 1 week ago
204 views
#RAS #Uturn # racewaysnursery மறுசுழற்சி நீர்வாழ் வளர்ப்பு அமைப்புகள் /இறால் குஞ்சு வளர்ப்புப் பண்ணை
Shared 1 month ago
30 views
Shared 1 month ago
308 views
Shared 1 month ago
157 views
Shared 3 months ago
205 views
Shrimp Toilet Concept | Sustainable Aquaculture Solution | Central drainage | கழிவு நீர் வெளியேற்றம்
Shared 3 months ago
1.1K views
Shared 4 months ago
84 views
மிதவை உயிரினங்கள் வளர்ச்சி கட்டுப்பாட்டு முறைகள் /Plankton Blooming & Control Methods #shrimpfarming
Shared 4 months ago
424 views
Shared 5 months ago
86 views
Shared 5 months ago
326 views
Shrimp farming success story|C.K.Sudhakaran| இறால் வளர்ப்பு|Malayalam|Part-3.#kerala #shrimp#monodon
Shared 5 months ago
687 views
Shared 6 months ago
355 views
Shared 6 months ago
448 views
Shrimp Farming Success Story | C.K. Sudhakaran Journey from Dubai to Vannamei Farming இறால் வளர்ப்பு
Shared 7 months ago
388 views
Shared 7 months ago
329 views
Nursery Shifting&Hapa Bed Benefits in Shrimp Farming/இறால் நர்சரி மாற்றம்&ஹப்பா படுக்கையின் நன்மைகள்
Shared 8 months ago
243 views
Nursery Seed Shifting in Shrimp Farming | Packing & Transport Tips/ கனிம கலந்த நீர்/ இறால் குஞ்சிகள்
Shared 8 months ago
235 views
Shared 8 months ago
538 views
Shrimp Broodstock Quarantine-Tamil, #RGCA #srilanka ,#Neelankarai #AQF , Aquatic quarantine facility
Shared 8 months ago
130 views
Shared 9 months ago
101 views
Shared 9 months ago
134 views
Shared 10 months ago
422 views
Shared 1 year ago
63 views
Shared 1 year ago
400 views
Shared 1 year ago
989 views
Shared 1 year ago
93 views
Shared 1 year ago
203 views
Shared 1 year ago
260 views
Essential Things to Know Before Starting a Shrimp Farming Business ,#aquaculture, இறால் பண்ணை,PART-1
Shared 1 year ago
569 views
Shared 1 year ago
97 views
Shared 1 year ago
113 views
Shared 1 year ago
252 views
Shared 1 year ago
71 views
Shared 1 year ago
122 views
Shared 1 year ago
1.2K views
Shared 1 year ago
165 views
Shared 1 year ago
169 views
Shared 1 year ago
317 views
Controlling black gill dissese in shrimp farming @blackgill @Shrimp @Aquaculture /கருப்பு கில் நோய்.
Shared 1 year ago
558 views
Shared 1 year ago
132 views
Shared 2 years ago
929 views
Shared 3 years ago
60 views
Shared 4 years ago
3.3K views
Shared 4 years ago
358 views
How to calculate ABW, Daily Feed, Total Biomass & No of seed stock in the Pond(#Shrimp farming)#Aqua
Shared 4 years ago
14K views
Shared 4 years ago
603 views
Shared 4 years ago
202 views
Shared 4 years ago
993 views
Shared 4 years ago
2.7K views
Shared 4 years ago
169 views
Shared 4 years ago
2.2K views